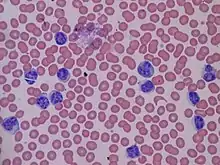

كثرة اللمفاويات
كثرةُ اللِمْفاوِيّات (بالإنجليزية: Lymphocytosis) هي زيادة في عدد الخلايا اللمفاوية (إحدى أنواع خلايا الدم البيضاء) . الخلايا الليمفاوية هي جزء مهم من نظام المناعة وهي مصنوعة من قبل الجهاز المناعي لمحاربة الأمراض .
| كثرة اللمفاويات | |
|---|---|
| معلومات عامة | |
| الاختصاص | علم الدم |
| من أنواع | كثرة الكريات البيض |
ويعتبر أعلى معدل من عدد الخلايا الليمفاوية في البالغين عندما يكون أكبر من 4000 لكل ميكروليتر اما في الأطفال يكون أكبر من 7000 لكل ميكروليتر والرضع أكبر من 9000 لكل ميكروليتر .[1] ، الخلايا الليمفاوية تمثل عادة 20 إلى 40٪ من خلايا الدم البيضاء.
وعادة ما يتم الكشف عن كثرة اللمفاويات عندما يتم اجراء عد دموي شامل . إذا لم يتم يتوفير عدد اللمفاويات يمكن أن تحسب بضرب مجموع خلايا الدم البيضاء(WBC) في نسبة الخلايا الليمفاوية الموجودة في العد التفريقي .[2] كما يمكن قياسها مباشرة بما يسمى قياس التدفق الخلوي .
إن كثْرةُ اللِمْفاوِيّات لا تعد مرض ولا تحتاج تدخل علاجي بحد ذاتها وانما يجب علاج المسبب الأساسي لها وهي بدورها تعود إلى نسبتها الطبيعية
الاسباب
ترتبط كثرة الخلايا الليمفاوية بالإصابة بعدوى (بكتيريا ، فيروس وغيرها) وخاصة في الأطفال. اما في كبار السن ترتبط باختلالات في الدم أو ما يسمى الاضطرابات التكاثرية اللمفية مثل سرطان الدم الليمفاوي المزمن وسرطان الغدد اللمفاوية والتي غالبا ما تكون مصحوبة بتضخم العقد اللمفاوية.
من الأسباب المعروفة والتي قد تؤدي للإصابة :
- العدوى الفيروسية الحادة، مثل كثرة الوحيدات العدوائية (الحمى الغدية )[3]، والتهاب الكبد [3] وعدوى الفيروس المضخم للخلايا [3]
- السعال الديكي.[3]
- سرطان الغدد اللمفاوية.
- سرطان الدم الليمفاوي المزمن .
- سرطان الدم الليمفاوي الحاد .
- التدخين [4]
- بعد استئصال الطحال.[5]
- السل [3] وداء البروسيلات أو الحمى المتموجة.[3]
ومن أسباب كثرة اللمفاويات النسبي ما يلي: سن أقل من 2 سنوات؛ العدوى الفيروسية الحادة؛ أمراض النسيج الضام، فرط نشاط الغدة الدرقية، مرض أديسون، وتضخم الطحال .
انظر أيضاً
- الخلايا اللمفاوية
- قلة اللمفاويات
- خلايا الدم البيضاء
- الجهاز المناعي
- الاضطرابات التكاثرية اللمفية
مراجع
- Miale, John B. Laboratory Medicine: hematology. 5th. St. Louis: C.V. Mosby, 1977.
- For example, if the total WBC count is 30,000, and the %lymphocytes is 30, the absolute lymphocyte count is 9,000 per لتر.
- Table 12-6 in: Mitchell, Richard Sheppard; Kumar, Vinay; Abbas, Abul K.; Fausto, Nelson (1997). Robbins Basic Pathology. Philadelphia: Saunders. ISBN 1-4160-2973-7. الوسيط
|CitationClass=تم تجاهله (مساعدة) 8th edition. - Freedman, DS; Flanders, WD; Barboriak, JJ; Malarcher, AM; Gates, L (July 1996). "Cigarette smoking and leukocyte subpopulations in men". Annals of epidemiology. 6 (4): 299–306. PMID 8876840. الوسيط
|CitationClass=تم تجاهله (مساعدة) - Juneja, S; Januszewicz, E; Wolf, M; Cooper, I (1995). "Post-splenectomy lymphocytosis". Clinical and laboratory haematology. 17 (4): 335–7. PMID 8697729. الوسيط
|CitationClass=تم تجاهله (مساعدة)
- بوابة طب
- بوابة علم الأحياء